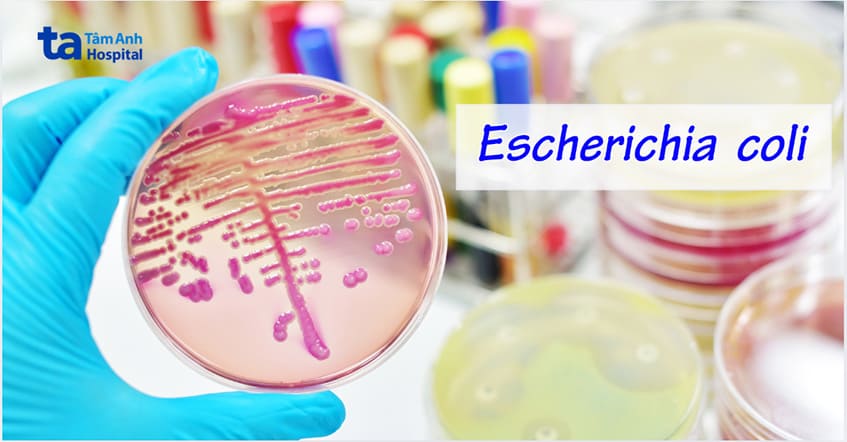
Vi khuẩn E.coli có khả năng phát triển kháng kháng sinh

Viêm bàng quang là bệnh đường tiết niệu thường gặp. Bệnh có thể được điều trị khỏi, tuy nhiên rất dễ tái phát khiến người bệnh thường lựa chọn tự mua thuốc kháng sinh để điều trị gây ra hiện tượng viêm bàng quang uống kháng sinh không khỏi.

Điều trị viêm bàng quang bằng thuốc khi có bằng chứng nhiễm khuẩn trong nước tiểu, phản ánh trong xét nghiệm nước tiểu thường quy hay nuôi cấy nước tiểu. Nếu triệu chứng không quá nặng, có thể điều trị bằng cách uống nhiều nước, nghỉ ngơi, hoặc có thể dùng thuốc kháng sinh, gồm kháng viêm non-steroid kết hợp với thuốc giảm co thắt, được kê đơn dựa trên từng tình trạng cụ thể. (1)
Những trường hợp viêm bàng quang nhẹ thường sẽ tự khỏi trong vòng vài ngày. Tuy nhiên, một số trường hợp thường xuyên bị viêm bàng quang, tái phát nhiều lần, cần tìm hiểu nguyên và có kế hoạch điều trị dài hạn hơn. Các triệu chứng chính của viêm bàng quang bao gồm:
Mặc dù hầu hết các trường hợp viêm bàng quang đều được điều trị bằng kháng sinh. Tuy nhiên, không phải lúc nào điều trị bằng kháng sinh cũng hiệu quả. Điều này dẫn đến thực tế rằng nhiều người bệnh viêm bàng quang uống kháng sinh không khỏi.

Có nhiều nguyên nhân gây viêm bàng quang uống kháng sinh không khỏi, có thể do các yếu tố khách quan và chủ quan. Cụ thể như sau:
Người bệnh tự ý ngừng dùng thuốc khi thấy bệnh đã thuyên giảm hoặc các triệu chứng đã biết mất. Tuy nhiên, điều này không đồng nghĩa với việc nhiễm trùng đã được loại bỏ hoàn toàn. Cho nên, bệnh dễ tái phát sau điều trị hoặc tái phát ngay sau thời gian ngắn ngừng dùng thuốc.
Uống thuốc không đúng liều, quên thuốc làm gián đoạn điều trị. Có nhiều lý do khiến người bệnh không sử dụng thuốc đều đặn, điều này sẽ làm kháng sinh giảm tác dụng. Nếu tình trạng này kéo dài, có thể khiến người bệnh đối mặt với nguy cơ kháng thuốc, khiến bệnh tiến triển xấu, làm phức tạp thêm quá trình điều trị, ảnh hưởng đến sức khỏe hệ tiết niệu và sức khỏe tổng thể.
Đa số nhiễm trùng đường tiểu dưới là do vi khuẩn E.coli. Tuy nhiên cũng có một số chủng vi khuẩn khác và vi khuẩn E. coli đề kháng kháng sinh sẽ không đáp ứng với những kháng sinh điều trị thông thường. Điều này cần những bác sĩ Tiết niệu có kinh nghiệm để lựa chọn kháng sinh thích hợp.
Chính vì vậy, khi khám và điều trị bất kỳ vấn đề gì về sức khỏe tiết niệu, người bệnh nên lựa chọn cơ sở khám chữa bệnh uy tín, chất lượng có đội ngũ bác sĩ đủ trình độ chuyên mô, năng lực, có hệ thống trang thiết bị chẩn đoán và điều trị tiên tiến. Điều này sẽ giúp người bệnh nhận được kết quả chẩn đoán chính xác và lựa chọn phác đồ điều trị phù hợp, hiệu quả.
Quan hệ tình dục tạo điều kiện cho vi khuẩn ngược dòng từ bên ngoài xâm nhập vào niệu đạo, bàng quang, gây khó khăn cho quá trình điều trị. Tuy nhiên, không phải tất cả các trường hợp quan hệ tình dục trong khi điều trị cũng khiến viêm bàng quang uống kháng sinh không khỏi. Điều này thường chỉ đúng trong trường hợp người bệnh là nữ, quan hệ với nhiều bạn tình, không dùng các biện pháp an toàn.
Thói quen sinh hoạt, vệ sinh kém cũng là nguyên nhân khiến nhiều người mắc viêm bàng quang uống kháng sinh không khỏi. Vì cấu tạo đặt biệt, bàng quang nối với niệu đạo và đoạn cuối của niệu đạo nối với bộ phận sinh dục. Cho nên, trong quá trình điều trị viêm bàng quang, người bệnh cần tuân thủ các chỉ định về vệ sinh cơ quan sinh dục đúng cách, thường xuyên.
Hơn nữa, một số người bệnh trong quá trình điều trị không kiêng quan hệ tình dục, thực hành chế độ ăn uống không lành mạnh, vẫn thường sử dụng rượu bia, thuốc lá, chất kích thích,… dễ khiến thuốc kháng sinh bị giảm tác dụng, dần dần gây kháng thuốc, dẫn đến mất hiệu quả điều trị viêm bàng quang của thuốc.
Lờn thuốc, kháng kháng sinh là khi vi khuẩn thay đổi để chống lại các loại kháng sinh được sử dụng để điều trị chúng. Điều này làm cho một số bệnh nhiễm trùng do vi khuẩn khó điều trị, trong đó có viêm bàng quang. Việc lạm dụng và dùng kháng sinh không đúng liều, sai cách gây ra hiện tượng kháng kháng sinh. (2)
Cơ thể không phát triển khả năng kháng kháng sinh, nhưng vi khuẩn thì có thể. Khi tình trạng kháng kháng sinh xảy ra, sẽ có ít kháng sinh có tác dụng chống lại 1 loại vi khuẩn cụ thể hơn. Các loại kháng sinh khác thường có tác dụng nhưng điều quan trọng là phải có càng nhiều lựa chọn điều trị càng tốt. Bắt đầu điều trị hiệu quả càng nhanh càng tốt đối với các bệnh nhiễm trùng nghiêm trọng.
Kháng kháng sinh rất nguy hiểm vì nó làm giảm các lựa chọn điều trị cho người bệnh, trì hoãn việc điều trị hiệu quả. Kết quả là, người bệnh có thể phải đối mặt:

Nếu viêm bàng quang chữa nhiều lần không khỏi, người bệnh có thể phải dùng thuốc suốt đời, nhưng điều này cũng tùy thuộc vào nguyên nhân, thời gian dùng thuốc có thể thay đổi.
Nếu bị viêm bàng quang liên tục tái phát do quan hệ tình dục, bác sĩ có thể kê đơn 1 liều kháng sinh duy nhất, uống trong vòng 2 giờ sau khi quan hệ tình dục. Trong trường hợp người bệnh đã trải qua thời kỳ mãn kinh, bác sĩ có thể kê đơn kháng sinh liều thấp trong tối đa 6 tháng hoặc sử dụng 1 loại kem estrogen âm đạo.
Ở một số phụ nữ, thuốc kháng sinh không có tác dụng hoặc xét nghiệm nước tiểu không phát hiện được tình trạng nhiễm trùng mặc dù có các triệu chứng viêm bàng quang. Điều này có nghĩa người bệnh bị nhiễm trùng bàng quang kéo dài (viêm bàng quang mạn tính) mà các xét nghiệm nước tiểu hiện tại không phát hiện được. Lúc này, bác sĩ sẽ cần có chiến lược điều trị chuyên sâu và lâu dài. Nhiễm trùng lâu dài có liên quan đến việc tăng nguy cơ ung thư bàng quang ở những người từ 60 tuổi trở lên.
Đối với nam giới, hiếm khi viêm bàng quang tái phát nhiều lần hoặc phát triển thành mạn tính. Khi có trường hợp này xảy ra, bác sĩ cần cân nhắc đến nguyên nhân gây nhiễm trùng, bệnh nền đi kèm và tình trạng viêm hiện tại, từ đó đưa ra phương án điều trị phù hợp. (3)
Biến chứng có thể gặp điều trị viêm bàng quang không khỏi có thể rất nguy hiểm.
Nhiễm trùng thận gây đau đớn và khó chịu thường do viêm bàng quang gây ra. Hầu hết những người bị viêm bàng quang sẽ không bị nhiễm trùng thận, nhưng đôi khi vi khuẩn có thể di chuyển từ bàng quang vào 1 hoặc cả 2 quả thận, khiến thận bị nhiễm trùng. Nguy hiểm hơn, nhiễm trùng đường tiết niệu dưới có thể nhanh chóng phát triển thành nhiễm trùng thận trong vài giờ đến vài ngày. (4)
Nếu được điều trị ngay bằng kháng sinh thì nhiễm trùng thận không gây tổn hại nghiêm trọng đến chức năng thận. Nếu nhiễm trùng thận không được điều trị, nó có thể trở nên nặng hơn và đôi khi gây tổn thương thận vĩnh viễn.
Nhiễm trùng thận có thể dẫn đến 1 tình trạng nguy hiểm gọi là liên kết nhiễm trùng huyết, có thể đe dọa đến tính mạng. Các triệu chứng của nhiễm trùng huyết bao gồm sốt, ớn lạnh, khó thở và nhịp tim nhanh, phát ban và lú lẫn. Nhiễm trùng thận trở nên mạn tính hoặc kéo dài có thể gây tổn thương không thể phục hồi cho thận.

Trong một số trường hợp, viêm bàng quang cấp tính, người bệnh có thể có máu trong nước tiểu (tiểu máu). Trong trường hợp viêm bàng quang cấp tính có tiểu máu, tiểu máu có thể là đại thể hoặc vi thể. Tiểu máu vi thể là khi người bệnh có tế bào máu trong nước tiểu, chỉ có thể nhìn thấy bằng kính hiển vi. Nước tiểu trông nhợt nhạt hoặc có màu vàng đậm.
Tiểu máu đại thể là khi có đủ máu trong nước tiểu mà người bệnh có thể nhìn thấy bằng mắt thường. Nước tiểu có thể có màu hồng hoặc đỏ, màu coca, màu trà. Việc lẫn máu trong nước tiểu gây thất thoát số lượng nhất định hồng cầu, nếu kéo dài, tình trạng này có thể gây thiếu máu.
Nguyên nhân rất phổ biến gây viêm bàng quang do vi khuẩn là E.coli, loại vi khuẩn này có thể di chuyển từ bàng quang vào vùng sinh dục, tử cung, ống dẫn trứng và buồng trứng và gây ra nhiều vấn đề. Nếu không được điều trị, nó có thể dẫn đến bệnh viêm vùng chậu, có khả năng gây các vấn đề về sinh sản trong tương lai.
Địa chỉ khám và điều trị viêm bàng quang uy tín tại TPHCM là khoa Tiết niệu, Trung tâm Tiết niệu – Thận học – Nam khoa, BVĐK Tâm Anh TP.HCM và Đơn vị Tiết niệu, Trung tâm khám chữa bệnh Tâm Anh Quận 7, với 100% bác được luân chuyển từ khoa Tiết niệu, Trung tâm Tiết niệu – Thận học – Nam khoa, BVĐK Tâm Anh TP.HCM. Với đội đội ngũ bác sĩ là những chuyên gia giàu kinh nghiệm, trình độ chuyên môn, y khoa sau đại học.
Cùng với đó là sự hỗ trợ của hệ thống trang thiết bị hiện đại, hệ thống Trung tâm Xét nghiệm nội bộ, trả kết quả nhanh chóng, giúp bác sĩ chẩn đoán chính xác tình trạng viêm bàng quang và đề ra phác đồ điều trị phù hợp cho từng cá nhân.

Dưới đây là một số lưu ý hỗ trợ điều trị viêm bàng quang hiệu quả, có thể tham khảo:
Như vậy, việc viêm bàng quang uống kháng sinh không khỏi do nhiều nguyên nhân khác nhau, từ khách quan đến chủ quan. Quan trọng hơn hết, người bệnh viêm bàng quang cần được chẩn đoán chính xác và điều trị kịp thời, bằng phác đồ phù hợp, tuân thủ chỉ định của bác sĩ trong suốt liệu trình, cho đến khi nhiễm trùng được loại bỏ hoàn toàn.
HỆ THỐNG BỆNH VIỆN ĐA KHOA TÂM ANH
Hy vọng với những thông tin bài viết vừa chia sẻ đã giúp bạn hiểu thêm về nguyên nhân khiến viêm bàng quang uống kháng sinh không khỏi, tuân thủ điều trị vẫn là yếu tố quan trọng trong điều trị viêm bàng quang hiệu quả.